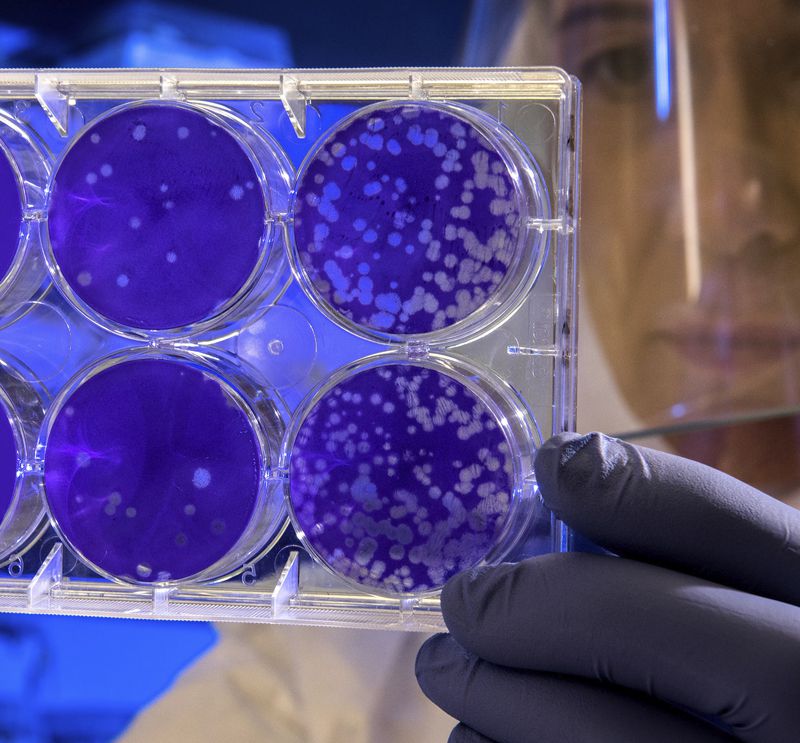

COVID-19 - CONSEJOS DESDE LA SALUD REGENERATIVA
Introducción
Desde que se inició la Pandemia del COVID-19, causada por el virus SARS-CoV-2, la comunidad científica no para de investigar y publicar artículos más o menos concluyentes, pero seguro, que todos son muy interesantes.
Desde Algēmica, hemos hecho una recoplicaión de algunos de estos artículos que hacen referencia a la rama de medicina integrativa y os los dejamos en este artículo con carácter informativo.
Es importante conocer el mecanismo de acción del Coronavirus y como aprovecha el receptor ACE2 (enzima convertidora de la Angiotensina) para entrar dentro las células respiratorias y intestinales, así como las células renales y cardíacas.
Todas las referencias de este artículo pueden encontrarse en el Pubmed, y en la plataforma científica Springer Nature, en abierto y en tiempo real.
UTRACÈUTICOS ACTIVOS EN PREVENCIÓN Y POSIBLES COADYUVANTES EN EL TRATAMIENTO DEL COVID-19
(con referencias científicas y plausibilidad biológica)
VITAMINAS A, E, C, B, D y MINERALES Se y Zn
Ya conocemos sobradamente estas vitaminas y estos minerales como antioxidantes, regeneradoras celulares, antimutagénicas (A y D), estimuladoras inespecíficas del sistema inmunitario, inmunomoduladoras frente a bacterias y virus, y reguladoras de la respuesta de distrés.
OMEGA 3 Y CILANTRO
Es de vital importancia que el cuerpo pueda responder de manera efectiva a la inflamación causada por el sistema inmunitario frente a la destrucción de células pulmonares o mucosas causada por CoV-2. Por ello, se recomienda el aporte extra de omega 3 y agentes antiinflamatorios como el extracto de cilantro.

NO (Óxido Nítrico)
El óxido nítrico actúa como neurotransmisor a nivel celular y tiene un papel antiinfeccioso y antinflamatorio capital, como puede ver en este artículo:
SISTEMA IMMUNOLÓGICO
El ON está relacionado con el sistema inmune, es efector de la citoxicidad mediada por macrófagos, inhibe la proliferación de células T, particularmente las T ayudadores tipo 1 (Th1), y ayuda a mantener el balance entre Th1 / Th2 importante en la respuesta inflamatoria y la función inmune (49). La concentración elevada de ON por la acción de la ONSi es necesaria para prevenir la sobre expansión de les células Th1, que están involucradas en el desarrollo de inflamación persistente o no controlada que produce choque severo y disfunción orgánica (49).
Para aumentar la cantidad de Óxido Nítrico a nivel celular necesitamos altos niveles de Coenzima Q10 y también una dosis importante de ciertos aminoácidos, como la L-arginina y la L-citrulina.
A nivel nutricional, encontramos alimentos con alta riqueza como el chocolate, las espinacas, la remolacha, el salmón, los camarones, el ajo, las nueces, el arroz integral, los cítricos, la pimienta de cayena, los frutos secos, el hígado, etc.
(49) Shigeki Miki, Naoshi Takeyama, Takaya Tanaka, Toshio Nakatani. Inmune disfunction in endotoxicosis: Role of Nitric oxide Produced by inducible Nitric oxide Synthase. Crit Care Med 2005 Vol. 33, No 4.
N-ACETILCISTEÍNA NAC (estudio 18)
Varios estudios han demostrado que entre 200mg y 600mg de NAC, tienen un efecto positivo en la prevención del COVID-19 i en la protección celular a nivel pulmonar, así como en la reparación y recuperación de los enterocitos.
La función más útil del NAC en la infección por CoV2 es por la gran capacidad que tiene de formación del Glutatión intracelular.
18.- Nutraceuticals have potential for boosting the type 1 interferon response to RNA viruses including influenza and coronavirus. Author links open overlay panel. Mark F.McCartyaJames J.DiNicolantoniob https://doi.org/10.1016/j.pcad.2020.02.007
GLUTATIÓN
“La evidencia de un deterioro en el complejo redox intracelular es esencial para el inicio y mantenimiento de la replicación del virus", así se refiere el documento científico del laboratorio de Estados Unidos, LABS. UNIPHARMA.
Referencias Bibliográficas
Wu F, Zhao S, Yu B, et al. A new coronavirus associated with human respiratory disease in China [published online ahead of print February 3, 2020]. Nature. https://doi:10.1038/s41586-020-2008-3.
Chen N, Zhou M, Dong X, et al. Epidemiological and clinical characteristics of This article is protected by copyright. All rights reserved. 99 cases of 2019 novel coronavirus pneumonia in Wuhan, China: a descriptive study [published online ahead of print January 30, 2020]. Lancet. https://doi:10.1016/S0140-6736(20)30211-7.
Wang D, Hu B, Hu C, et al. Clinical characteristics of 138 hospitalized patients with 2019 novel coronavirus-infected pneumonia in Wuhan, China [published online ahead of print February 7, 2020]. JAMA. https://doi:10.1001/jama.2020.1585.
Lu Ru R, Zhao XZhao X, Li JLi J, et al.et al. Genomic characterisation and epidemiology of 2019 novel coronavirus: implications for virus origins and receptor binding [published online ahead of print January 30, 2020]. Lancet. https://https://doi:10.1016/S0140doi:10.1016/S0140-6736(20)302516736(20)30251-8
Chai Z, Hu L, Zhang Y, et al. Specific ACE2 expression in cholangiocytes may cause liver damage after COVID-19 infection [published online as preprint February 4, 2020]. BioRxiv. https://doi:10.1101/2020.02.03.931766
Hashimoto T, Perlot T, Rehman A, et al. ACE2 links amino acid malnutrition to microbial ecology and intestinal inflammation. Nature. 2012;487(7408):477–481.
Bradley KC, Finsterbusch K, Schnepf D, et al. Microbiota-driven tonic interferon signals in lung stromal cells protect from influenza virus infection. Cell Rep. 2019;28(1):245-256.e4.
[Management of Corona Virus disease-19 (COVID-19): The Zhejiang Experience] – PubMed [Internet]. [cited 2020 Mar 4]. Available from: https://pubmed.ncbi.nlm.nih.gov/32096367- management-of-corona-virus-isease-19-covid-19-the-zhejiang-experience/? from_term=covid-19+AND+microbiome&from_pos=1
Shanghai Government Officially Recommends Vitamin C for COVID-19 [Internet]. [cited 2020 Mar 4]. Available here.
Habibzadeh P, Stoneman EK. The Novel Coronavirus : A Bird ’ s Eye View. 2020;
Health M. COVID-19 : what is next for public health ? 2020;395.
Hemilä H. Vitamin C and infections. Vol. 9, Nutrients. MDPI AG; 2017.
Kuba K, Imai Y, Rao S, Gao H, Guo F, Guan B, et al. A crucial role of angiotensin converting enzyme 2 (ACE2) in SARS coronavirus-induced lung injury. Nat Med. 2005 Aug 10;11(8):875– 9.
1Liu Y-S, Liu Q, Jiang Y-L, Yang W-T, Huang H-B, Shi C-W, et al. Surface-displayed porcine IFN- λ3 in Lactobacillus plantarum inhibits porcine enteric coronavirus infection of porcine intestinal epithelial cells. J Microbiol Biotechnol. 2019;
Liu Y, Zhang L, Liu Y, Liu Y, Hospital S, District H, et al. Title: Potential Interventions for Novel Coronavirus in China: A Systematic Review. 0–2 p.
Sencio V, Barthelemy A, Tavares LP, Machado MG, Soulard D, Cuinat C, et al. Gut Dysbiosis during Influenza Contributes to Pulmonary Pneumococcal Superinfection through Altered Short-Chain Fatty Acid Production. Cell Rep [Internet]. 2020 Mar 3 [cited 2020 Mar 4];30(9):2934-2947.e6. Available from: https://linkinghub.elsevier.com/retrieve/pii/S2211124720301674
Yu M, Wang L, Ma S, Wang X, Wang Y, Xiao Y, et al. Immunogenicity of eGFP-Marked Recombinant Lactobacillus casei against Transmissible Gastroenteritis Virus and Porcine Epidemic Diarrhea Virus. Viruses [Internet]. 2017 Sep 25 [cited 2020 Mar 4];9(10):274. Available here.
Mela S, Whitworth DE. The fist bump: a more hygienic alternative to the handshake. Am J Infect Control. 2014;42(8):916–917. doi:10.1016/j.ajic.2014.04.011
Washed Microbiota Transplantation for Patients With 2019-nCoV Infection, en https://clinicaltrials.gov/ct2/show/NCT04251767?cond=COVID-19&draw=4&rank=
Nutraceuticals have potential for boosting the type 1 interferon response to RNA viruses including influenza and coronavirus Author links open overlay panel Mark F.McCartyaJames J.DiNicolantoniob https://doi.org/10.1016/j.pcad.2020.02.007